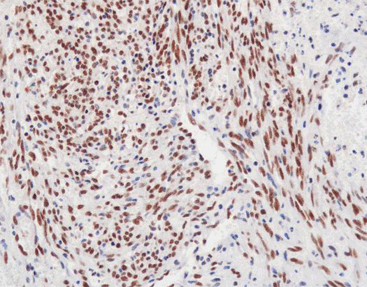

PRODUCT CATEGORY
PRODUCT CATEGORY
CONTACT US
FLI-1
FLI-1 genes and FLI-1 proteins are known because it plays important roles in the pathogenesis of ewing's sarcoma/peripheral neuroectoblastoma (ES/PNET). FLI-1 was first utilized in the diagnosis, specificity and sensitivity of Ewing's sarcoma/peripheral primitive neuroectodermal tumors to CD99. In recent researches, they have confirmed that the FLI-1 gene also plays an important role in the embryonic development of blood vessels. It is expressed in all types of vascular endothelial cells in the human body (arterial vein and lymphatic), and the positive rate of angiosarcoma is as high as 90% , as well as expresses lymphoblast lymphoma.
The antibody is now recommended for utilizing in combination with CD99 to identify Ewing's sarcoma or peripheral neuroblastoma (ES/PNET). To do differential diagnosis of vascular endothelial tumor ,especially between epithelioid vascular endothelial tumors and epithelial tumors.
Staining Tissue
- As Figure shows:
Intrauterine endovascular tumor tissue stained with FLI-1
Specification
|
CODE |
WORKING SOLUTION |
CONCENTRATED SOLUTION |
||||
|
CFM-0041 |
SPECIFICATION |
1ml |
3ml |
6ml |
0.1ml |
0.2ml |
More Info
Clone: G146-222
Source: Mouse
Localization: Nucleus
Pretreatment: Thermal remediation
Applicable tissue: Paraffin section
Related Product

Chat
Chat

 message
message

 Quote
Quote



